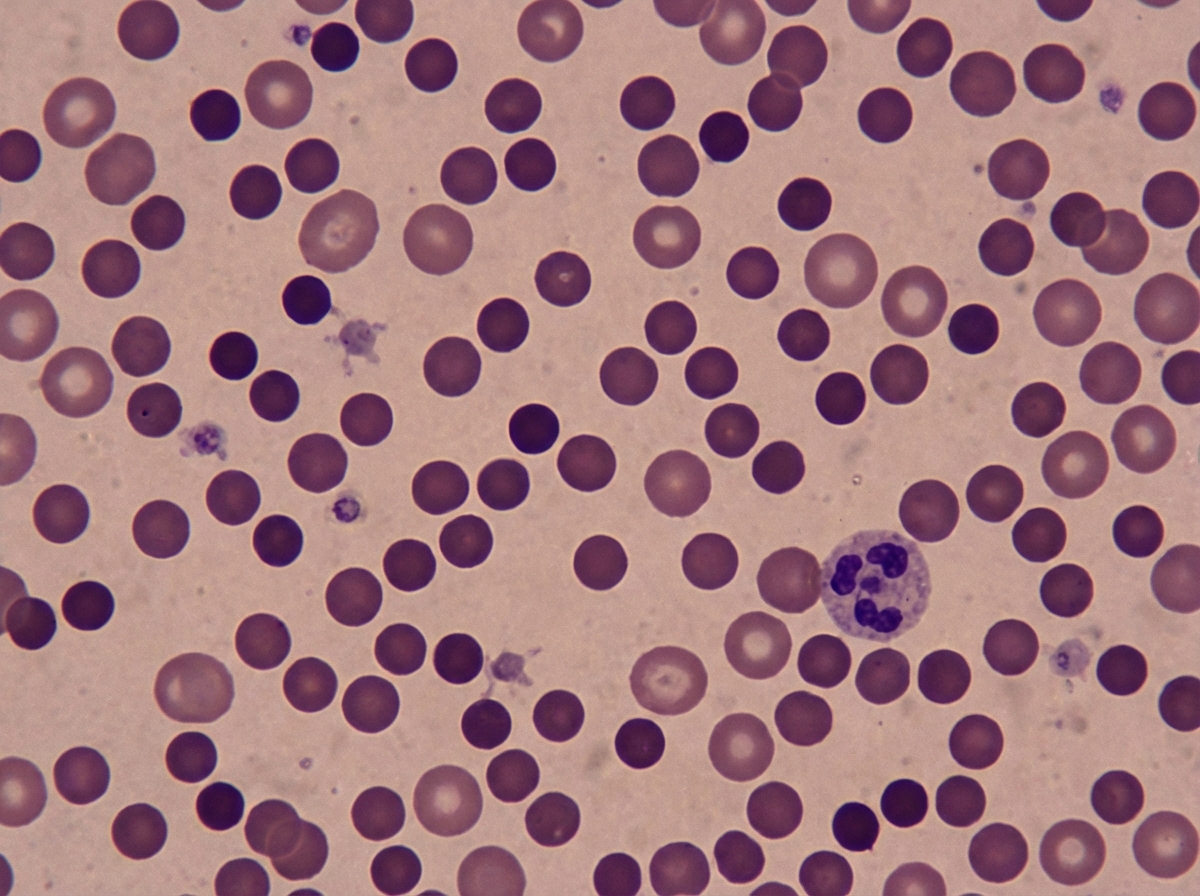
Image for question 224

Enter your email to get your 85% OFF code and unlock the full USMLE question bank on the app.
A 36-year-old man presents with massive hematemesis. Past medical history is significant for a gastric ulcer. He has a pulse of 115/min, respiratory rate of 20/min, temperature of 36°C (96.8°F), and blood pressure of 90/59 mm Hg. The patient receives a transfusion of 2 units of packed red blood cells. Around 5–10 minutes after the transfusion, he starts having chills, pain in the lumbar region, and oliguria. His vital signs change to pulse of 118/min, respiratory rate of 19/min, temperature of 38°C (100.4°F), and blood pressure of 60/40 mm Hg. Which of the following is the most likely cause of this patient’s condition?
A 59-year-old patient presented to his family physician 8 years ago with initial complaints of increasing generalized stiffness with trouble initiating movement and worsening micrographia. He was started on levodopa after further evaluation led to a suspected diagnosis of Parkinson's disease; however, this therapy ultimately failed to improve the patient's symptoms. Additionally, over the ensuing 8 years since his initial presentation, the patient also developed symptoms including worsening balance, orthostatic hypotension, urinary incontinence, and impotence. The patient's overall condition deteriorated ever since this initial diagnosis with increasing disability from his motor symptoms, and he recently passed away at the age of 67, 8 years after his first presentation to his physician. The family requests an autopsy. Which of the following would be expected on autopsy evaluation of this patient's brain tissue?
A 10-year-old boy presents to your office with puffy eyes. The patient's mother states that his eyes seem abnormally puffy and thinks he may have an eye infection. Additionally, he had a sore throat a week ago which resolved with over the counter medications. The mother also thought that his urine was darker than usual and is concerned that blood may be present. His temperature is 99.5°F (37.5°C), blood pressure is 107/62 mmHg, pulse is 100/min, respirations are 17/min, and oxygen saturation is 98% on room air. Physical exam is notable for bilateral periorbital edema. Cranial nerves are grossly intact bilaterally. Which of the following is the most likely finding on renal biopsy for this patient?
A 37-year-old man, otherwise healthy, has a routine CBC done prior to donating blood for the first time. The results are as follows: Hemoglobin 10.8 g/dL Mean corpuscular volume (MCV) 82 μm3 Mean corpuscular hemoglobin concentration (MCHC) 42% Reticulocyte count 3.2% White blood cell count 8,700/mm3 Platelet count 325,000/mm3 The patient is afebrile and his vital signs are within normal limits. On physical examination, his spleen is just palpable. A peripheral blood smear is shown in the exhibit (see image). A direct antiglobulin test (DAT) is negative. Which of the following best describes the etiology of this patient’s most likely diagnosis?
A 5-year-old boy is brought to the physician because of a painful, burning rash on his left arm for 3 days. Three years ago, he was diagnosed with heart failure due to congenital heart disease and received an allogeneic heart transplantation. He takes cyclosporine to prevent chronic transplant rejection. He has not received any routine childhood vaccinations. A photograph of the rash is shown. Microscopic examination of a skin biopsy specimen is most likely to show which of the following findings?

A 21-year-old man comes to the physician because of a 3-day history of yellowing of his eyes. He has also noticed a decrease in his exercise capacity and gets quickly exhausted after minor physical activity. Examination shows scleral icterus and pale mucous membranes. He has splenomegaly. His hemoglobin concentration is 7.9 g/dL, leukocyte is count 8500/mm3, and platelet count is 187,000/mm3. Direct antiglobulin and heterophile antibody tests are positive. Which of the following additional laboratory findings are most likely present in this patient?
A pathologist performed an autopsy on an 18-month-old infant boy who died of pneumonia. Clinical notes revealed the infant had repeated respiratory infections that started after he was weaned off of breast-milk. Laboratory investigation revealed hypogammaglobulinemia and an absence of B-cells. T-cell levels were normal. Histological evaluation of an axillary lymph node revealed an absence of germinal centers. Which of the following is the mode of inheritance of the disorder that afflicted this infant?
A 12-year-old boy comes to the physician for the evaluation of intermittent blood-tinged urine for several months. Four months ago, he had an episode of fever and sore throat that resolved without treatment after 5 days. During the past 2 years, he has also had recurrent episodes of swelling of his face and feet. 5 years ago, he was diagnosed with mild bilateral sensorineural hearing loss. His brother died of a progressive kidney disease at the age of 23. The patient appears pale. His temperature is 37°C (98.6°F), pulse is 70/min, and blood pressure is 145/85 mm Hg. Slit lamp examination shows a conical protrusion of both lenses. Laboratory studies show a hemoglobin concentration of 11 g/dL, urea nitrogen concentration of 40 mg/dL, and creatinine concentration of 2.4 mg/dL. Urinalysis shows: Blood 2+ Protein 1+ RBC 5–7/hpf RBC casts rare Which of the following is the most likely underlying cause of this patient's symptoms?
A 3-month-old is referred to a pediatric immunologist by his pediatrician for further workup of recurrent sinopulmonary infections which have not abated despite adequate treatment. During the workup flow cytometry demonstrates a decrease in normal CD40L cells. Based on these findings, the immunologist decides to pursue a further workup and obtains immunoglobulin levels. Which of the following immunoglobulin profiles is most likely to be observed in this patient?
A 31-year-old man presents to the office with complaints of multiple episodes of blood in his urine as well as coughing of blood for the past 3 days. He also reports a decrease in urinary frequency, and denies pain with urination. No previous similar symptoms or significant past medical history is noted. There is no history of bleeding disorders in his family. His vitals include a blood pressure of 142/88 mm Hg, a pulse of 87/min, a temperature of 36.8°C (98.2°F), and a respiratory rate of 11/min. On physical examination, chest auscultation reveals normal vesicular breath sounds. Abdominal exam is normal. The laboratory results are as follows: Complete blood count Hemoglobin 12 g/dL RBC 4.9 x 106 cells/µL Hematocrit 48% Total leukocyte count 6,800 cells/µL Neutrophils 70% Lymphocyte 25% Monocytes 4% Eosinophil 1% Basophils 0% Platelets 200,000 cells/µL Urine examination pH 6.2 Color dark brown RBC 18–20/HPF WBC 3–4/HPF Protein 1+ Cast RBC casts Glucose absent Crystal none Ketone absent Nitrite absent 24 hours urine protein excretion 1.3 g A renal biopsy under light microscopy shows a crescent formation composed of fibrin and macrophages. Which of the following best describes the indirect immunofluorescence finding in this condition?
Liver pathology (hepatitis, cirrhosis)
Practice Questions
Gallbladder and biliary tract disorders
Practice Questions
Pancreatic diseases
Practice Questions
Kidney diseases
Practice Questions
Male reproductive pathology
Practice Questions
Female reproductive pathology
Practice Questions
Breast pathology
Practice Questions
Endocrine pathology
Practice Questions
Bone and joint pathology
Practice Questions
Skeletal muscle diseases
Practice Questions
Peripheral nerve disorders
Practice Questions
Soft tissue tumors
Practice Questions
Head and neck pathology
Practice Questions
Get full access to all questions, explanations, and performance tracking.
Scan to download app